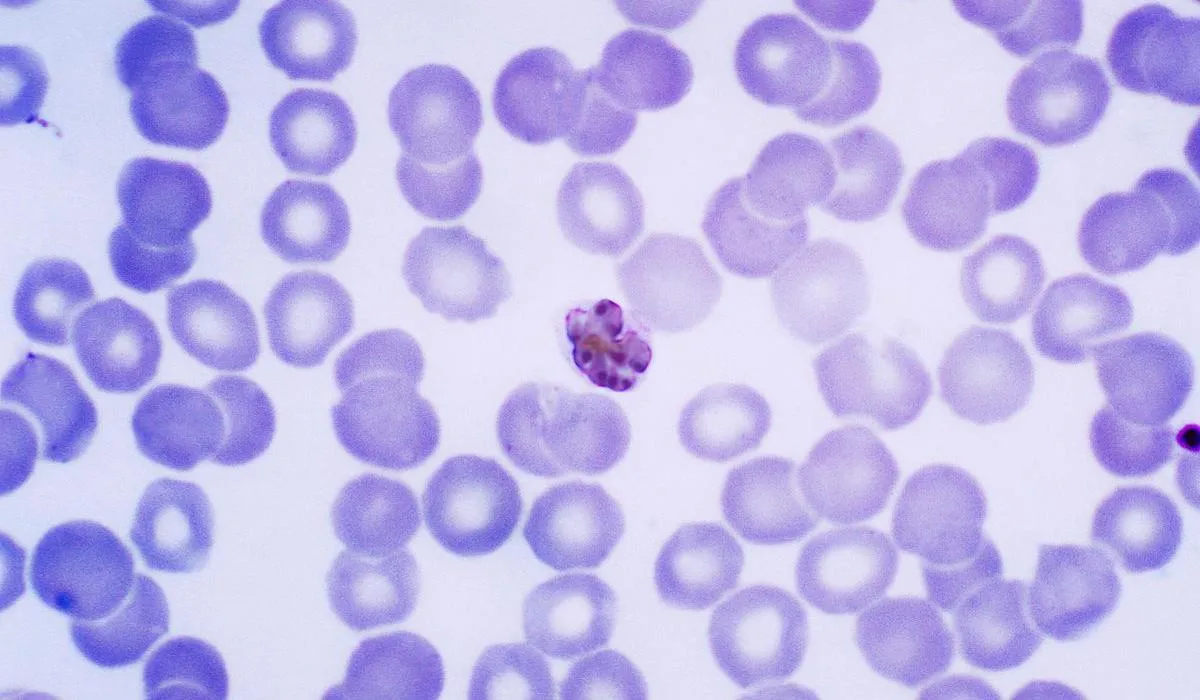
Червоні кров’яні тільця, заражені P. vivax Червоні кров’яні тільця, заражені P. vivax

Малярія: історія, статистика і поширення
Малярія або "болотяна лихоманка" – це інфекційне захворювання, яке передається людині при укусах так званих "малярійних комарів" (Anopheles). 80-90% пацієнтів, які підхопили тропічну малярію, помирають.
До теми Гепатити А, В і С: симптоми, лікування, профілактика
На думку медиків, малярія є однією з найнебезпечніших хвороб людства. В історії вона ставала причиною занепаду великих країн, народів й навіть "вирішувала" результати війн.
Саме від малярії померли такі відомі люди, як Чингісхан, Александр Македонський, король гунів Аттіла, святий Августин, Данте Аліг'єрі, Христофор Колумб, Олівер Кромвель, лорд Байрон та багато інших.
Дослідники вважають, що малярія з'явилась у Західній та Центральній Африці та розвивалас разом з людством. Археологи знайшли найстаріші скам'янілості комарів із залишками малярійних паразитів, вік яких становить 30 мільйонів років.
Особливо малярія поширюється і Субсахарській Африці, Бразилії, Шрі-Ланці, Індії, В'єтнамі та Колумбії. Загалом у місцях, де є малярійні комарі, мешкає 2,4 мільярда людей (близько 40% населення світу)
Малярія: географія небезпечних районів
За даними ВООЗ, станом на 2018 рік малярією захворіло 228 мільйонів людей, понад 405 тисяч з яких померло. Найважче малярію переносять діти до 5 років і 67% від усіх летальних випадків через малярію становлять саме вони.
Кількість щорічних летальних випадків через малярію більша, ніж через пневмонію та туберкульоз.
Малярія: зараження і симптоми
Малярія потрапляє у кров людини через укус самки малярійного комара. Також вона може передаватися внутрішньоутробно від зараженої матері дитині, під час переливання зараженої крові чи при ін'єкції шприцом.
Важливо Все про цукровий діабет: перші симптоми, профілактика і фактори ризику
Коли кров доставляє паразита до печінки, – він там визріває та розмножується, внаслідок чого руйнує червоні кров'яні клітини нашого тіла (еритроцити).
Після того, як якась клітина печінки руйнується, паразити вивільняються в організм та вражають еритроцити (червонокрівці) інфікованої особи, де продовжують розмножуватись. Згодом червонокрівці руйнуються й паразити вивільняються з них та вражають наступні еритроцити.
Коли клітина печінки руйнується і вивільнює паразитів, вони починають вражати еритроцити
Симптоми малярії можуть виникнути через 1-4 тижні після зараження та проходять досить важко.
Зазвичай малярії протікає циклічно – загострення захворювання триває від 6 до 10 годин. Після цього температура тіла знижується, але відбувається сильне потовиділення і настає глибокий сон (від 2 до 5 годин). Повторне загострення симптомів настає через 48-72 години.
Малярія лікується лише стаціонарно під пильним контролем медиків. Проблема у тому, що у малярійних паразитів розвинулася стійкість до деяких антибіотиків, внаслідок чого лікувати це захворювання стає все важче.
Чому малярія така небезпечна: симптоми, профілактика та лікування / Інфографіка 24 каналу
Малярія: профілактика захворювання
Якщо ви збираєтеся до країни, де поширена малярія, єдиний спосіб уникнути зараження – вакцинація, яку призначають за два тижні до поїздки.
Обирайте помешкання з антимоскітними сітками, кондиціонерами чи вентиляторами (якщо ці прилади увімкнені, вони можуть відлякувати комах). Не забувайте користуватись спреями проти комарів й носіть на вулиці закритий одяг світлого кольору.
Читайте також: Чим так небезпечна дифтерія: симптоми, профілактика і лікування
Уникайте чагарників, адже це улюблені місця для роїння небезпечних комарів. Також дуже небезпечними є місця із застійною водою – тут комахи розмножуються.
Не варто нехтувати й антимоскітними сітками над ліжками – вони мають бути суцільними, без дірок та обробленими інсектицидами (хімічні препарати для захисту рослин від шкідливих комах). Втім, у деяких районах малярійні комарі вже виробили стійкість до інсектицидів.
Якщо ви помітили у себе симптоми захворювання – негайно зверніться до лікаря.
Червоні кров’яні тільця людини, заражені паразитом виду Plasmodium vivax
Малярія в Україні
В Україні не циркулює збудник малярії. Переважна більшість випадків завезена з інших країн.
У 2016 році в Україні зареєстрували 43 завезених випадки малярії, один із постраждалих помер. У 2017 році в Україні зареєстровано 45 завезених випадків малярії (у 28 випадках на малярію захворіли громадяни України, у 17 – іноземці), троє постраждалих померли.
У 2018 році в Україні зареєстровано 19 завезених випадків малярії в тому числі 3 летальні випадки.
У 2019 році в Україну завезено 38 випадків малярії, з них двоє хворих померло.
Останні випадки у 2020 році, про які відомо:
- 8 липня у Львові в 46-річного чоловіка, який тривалий час працював в Африці, виявили найважчий вид малярії – тропічну малярію.
- 22-річний студент приїхав в Україну для навчання у Харківському ВНЗ 3 вересня минулого року. Перші симптоми з’явилися ще 9 травня: студент відчув слабкість, біль у горлі, температура тіла підвищилася до 37°C.